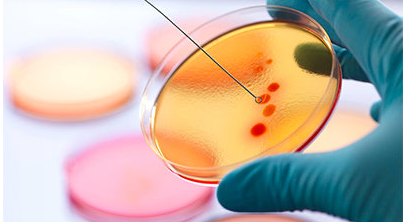

温州作为浙江省的一个重要城市,在医疗水平方面也是备受关注的。近年来,许多家庭选择前往温州寻求生育帮助,其中包括试管婴儿技术。
那么,在温州哪家医院开展的试管婴儿服务最好呢?这需要综合考虑多个因素,例如医院的技术实力、医生的经验、成功率等。为了帮助大家更好地了解温州的试管婴儿环境,我整理了一些信息供参考。
温州拥有众多专业的医疗机构,在提供试管婴儿服务方面也各有优势。如果你正在考虑选择温州进行试管婴儿治疗,可以优先关注以下几家医院:
温州市妇幼保健院
温州市妇幼保健院作为市级重点三甲医院,拥有强大的医疗团队和先进的设备设施,在助孕领域积累了丰富的经验。他们提供全面的试管婴儿服务,从咨询、检查到手术等环节都具有较高水平。
温州医学院附属第一医院
温州医学院附属第一医院是一所综合性三甲医院,也是浙江省重点建设的专科医院之一。他们拥有国内领先的胚胎实验室和先进的辅助生殖技术,在试管婴儿领域取得了不错的成绩。此外,他们还注重患者的体验,提供人性化的服务流程。
选择一家合适的医院是试管婴儿治疗的关键。除了以上提到的两家医院外,温州还有其他优秀的医疗机构,可以根据个人需求和预算进行选择。
浙江大学医学院附属邵逸夫医院
该医院作为国家级三甲医院,在生殖医学方面具有很强的实力,拥有资深专家团队和先进的诊疗技术。他们为患者提供个性化方案,并注重术后跟踪服务,以确保患者获得最佳的治疗效果。
试管婴儿是一种复杂的医疗技术,需要谨慎选择医院和医生。在进行试管婴儿治疗前,建议咨询专业医师,详细了解相关信息,做好充分准备。
以下是一些关于温州试管婴儿的注意事项:
费用预算
温州试管婴儿的费用因医院、方案和个体情况而异。一般来说,一次完整的试管婴儿流程大约需要花费6-8万元人民币。
成功率参考
不同的医院和医生拥有不同的成功率。选择医院时,可以咨询医生的成功率,并了解其成功率的统计依据。一般来说, reputable 温州试管婴儿医院的成功率在 60%-75%之间。
心理准备
试管婴儿是一个需要耐心和毅力的过程。患者需做好充分的心理准备,保持积极乐观的心态,与医生保持沟通,共同面对挑战。
Tips: 选择合适的医院进行试管婴儿治疗至关重要。建议提前做好功课,收集相关信息,并咨询专业的医师,以获得最佳的治疗方案和结果.






















 医院 · 516多所试管婴儿医院
医院 · 516多所试管婴儿医院
 医生 · 2497位试管婴儿医生
医生 · 2497位试管婴儿医生
 同龄 · 100万姐妹试管好孕群
同龄 · 100万姐妹试管好孕群
